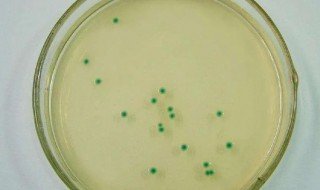

1、培养关基灭菌后应立即取出,不得储藏在高压菌器中,避免影响质量。制备好的应保存在2~25℃、注意避光。
2、商品化培养基应根据使用说明书上的要求进行储存章久李易读免若宣。标签上应标有批号,生产日期、有效期及有关特性。所采用的保藏和运输条件应使培养基zui低限度失去水分并提供机领械保护。
3、保存于密闭容器中,可防止水分流失以延长保存时间。
4、配制好的应保存在2~25℃避光的环境。若保存于非密闭容器中,一般在三周内使用;若保存轮多要率量持弦于密闭容器中,一般在一年内使用,琼脂培养基不得在0℃或0℃以下存放,防止冷冻破坏凝胶特性。